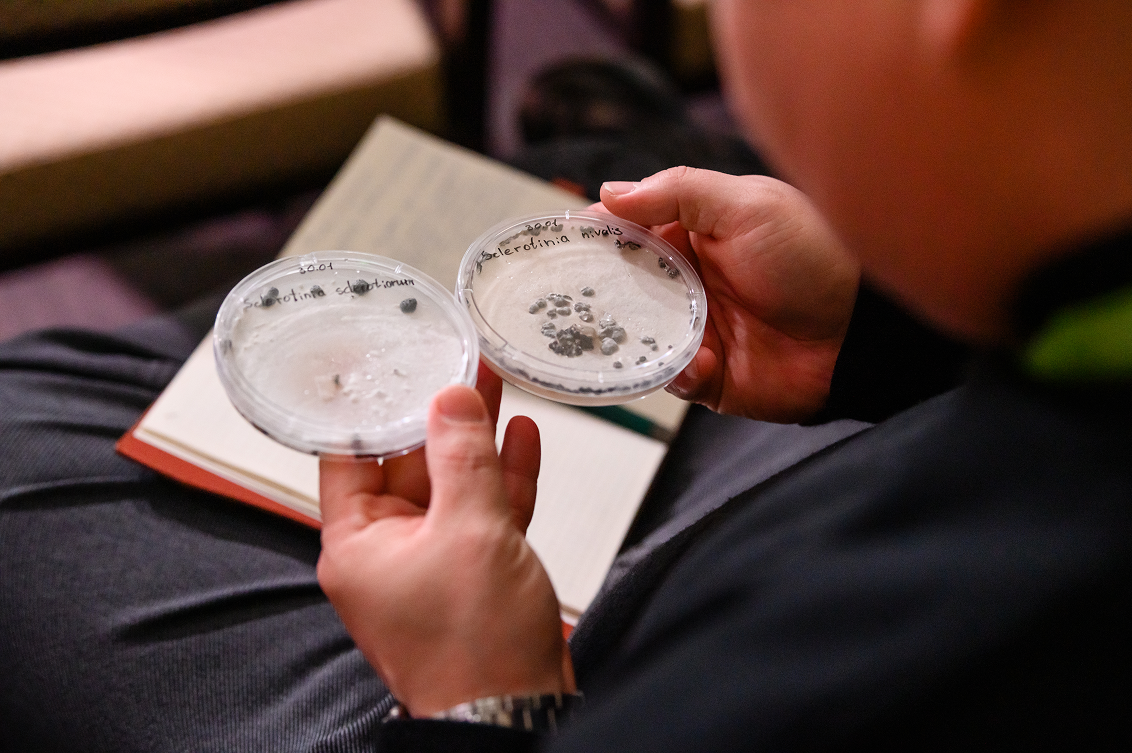

ОВОЩНАЯ
КОНФЕРЕНЦИЯ

Для аграриев нового времени!
Ведущие эксперты отрасли овощеводства представят российским аграриям актуальные тренды развития овощного рынка и передовые решения компании «Сингента». В программе конференции будут рассмотрены ключевые аспекты выращивания картофеля, эффективные методы борьбы с основными заболеваниями овощных культур, включая фузариозную гниль донца лука, гнили капусты, а также ложную мучнистую росу и фитофтороз. Особое внимание будет уделено перспективам развития рынка бахчевых культур.
Участники получат доступ к практическим рекомендациям по повышению эффективности производства и актуальным решениям для защиты овощных культур.
Это мероприятие станет ключевой площадкой для тех, кто стремится максимизировать рентабельность своего производства и быть в курсе последних тенденций отрасли.

10:30